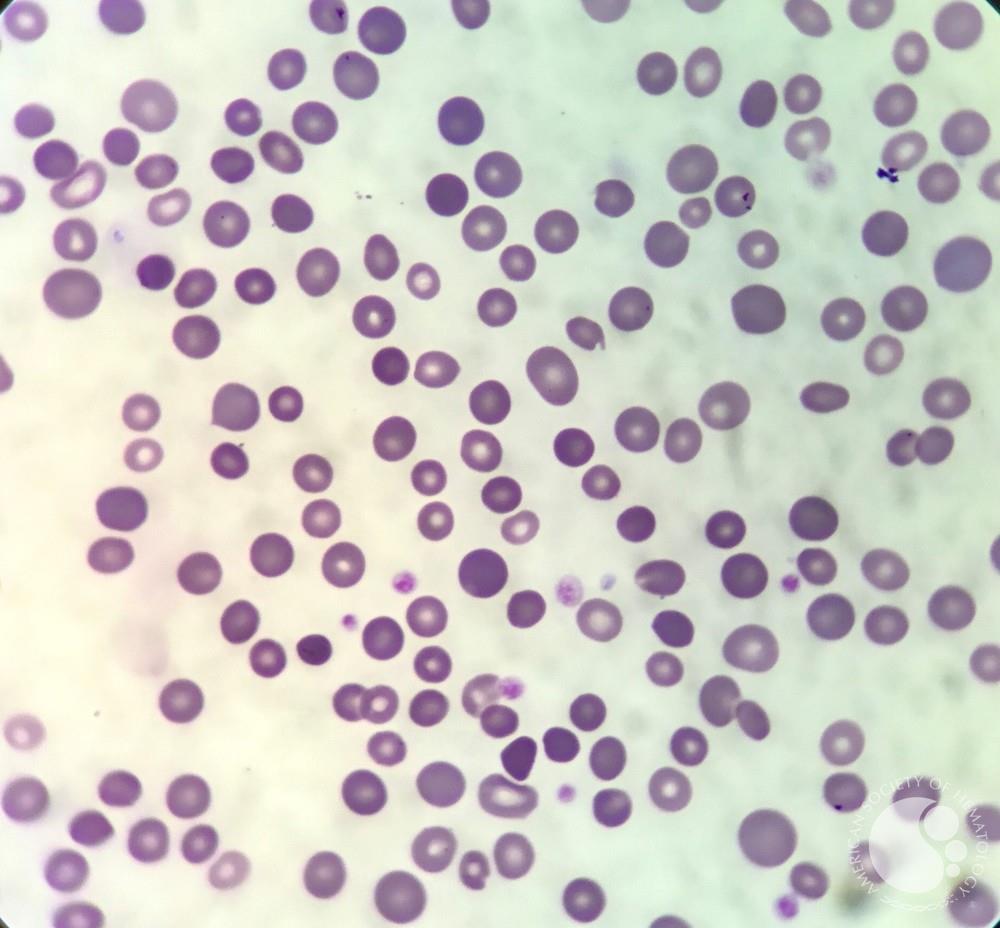

اسفروسیتوز ارثی (Hereditary Spherocytosis): علت، علائم، آزمایشها و درمان
اسفروسیتوز ارثی یک آنمی همولیتیک مادرزادی است که ناشی از نقص پروتئینهای غشای گلبول قرمز است و با گلبولهای قرمز کرویشکل، همولیز خارجعروقی و افزایش MCHC مشخص میشود. تشخیص بر پایه یافتههای بالینی، اسمیر خون محیطی، افزایش رتیکولوسیت و تستهای اختصاصی مانند EMA binding است و درمان در موارد متوسط تا شدید اغلب شامل اسپلنکتومی همراه با مراقبتهای واکسیناسیون و پیشگیری از عفونت است.
جهت عضویت در کانال آموزشی در تلگرام به لینک زیر مراجعه کنید:
https://t.me/hematology_education
فهرست مطالب
پیش از مطالعه ی این مقاله می توانید جهت مطالعه جامع در مورد طبقه بندی آنمی ها به لینک زیر مراجعه کنید:
طبقه بندی آنمی ها: راهنمای کامل تشخیص انواع کم خونی بر اساس اتیولوژی و مورفولوژی سلول
فیزیولوژی و پاتوفیزیولوژی بیماری / Pathophysiology و ساختار غشای RBC
گلبول قرمز طبیعی ساختاری دو لایه و انعطافپذیر دارد که به آن امکان عبور از مویرگهای باریک و سینوزوئیدهای طحال را میدهد. این شکل توسط شبکهای از پروتئینهای غشایی حفظ میشود.
غشای گلبول قرمز از دو بخش تشکیل شده است:
- دو لایه فسفولیپیدی که پروتئینهای تراغشایی در آن قرار دارند (مانند بند 3 و گلیکوفرینها).
- اسکلت زیرغشایی (membrane skeleton) که از پروتئینهایی مانند اسپکترین، آنکیرین، پروتئین 4.1 و پروتئین 4.2 ساخته شده است.
در اسفروسیتوز ارثی، نقص در یکی از این پروتئینها سبب میشود اتصال اسکلت به غشا ضعیف شود. در نتیجه، سلول در حین عبور از مویرگها و طحال، بخشی از سطح غشایی خود را از دست میدهد بدون اینکه حجم داخل سلول کاهش یابد.
به همین علت نسبت سطح به حجم سلول کاهش یافته و گلبول قرمز به شکل کروی (spherical) درمیآید.
این اسفروسیتها به دلیل کاهش انعطافپذیری در سینوزوئیدهای طحال گیر افتاده و توسط ماکروفاژها تخریب میشوند. بنابراین، نوع همولیز در این بیماری خارجعروقی (extravascular hemolysis) است.
ژنتیک بیماری / الگوی وراثت و ژنهای درگیر (Genetics – Inheritance)
اسفروسیتوز ارثی در بیشتر موارد با الگوی وراثت اتوزومال غالب (Autosomal dominant) منتقل میشود، هرچند حدود 25٪ از بیماران دارای فرم اتوزومال مغلوب یا جهشهای جدید هستند.
ژنهای درگیر و پروتئینهای مربوط عبارتاند از:
| ژن | پروتئین معیوب | نقش پروتئین |
| ANK1 | آنکیرین | اتصال اسپکترین به بند 3 |
| SPTA1 / SPTB | اسپکترین آلفا و بتا | شبکه اسکلتی غشا |
| SLC4A1 | بند 3 (Band 3) | تبادل کلر و بیکربنات؛ اتصال اسکلت به غشا |
| EPB42 | پروتئین 4.2 | پایداری کمپلکس بند 3 |
شدت بیماری بسته به نوع و میزان نقص متفاوت است. کمبود اسپکترین معمولاً شدیدترین فرم را ایجاد میکند، در حالیکه نقص پروتئین 4.2 معمولاً خفیفتر است.
تظاهرات بالینی / علائم بالینی و نشانهها (Clinical Presentation)
شدت تظاهرات بالینی بسیار متغیر است و از افراد بدون علامت تا بیماران مبتلا به آنمی شدید مشاهده میشود.
علائم شایع عبارتاند از:
- زردی (Icterus): در اثر افزایش بیلیروبین غیرمستقیم ناشی از همولیز.
- رنگپریدگی و خستگی: بهعلت کاهش هموگلوبین.
- بزرگی طحال (Splenomegaly): علامتی ثابت در اغلب بیماران، بهویژه در کودکان.
- سنگ صفراوی پیگمانته: بهدلیل رسوب بیلیروبین در صفرا، بهخصوص در نوجوانان و بزرگسالان.
- بحرانهای همولیتیک: معمولاً پس از عفونتهای ویروسی (مانند پاروویروس B19) که منجر به افزایش تخریب RBCها میشود.
- بحران آپلاستیک: زمانی رخ میدهد که تولید گلبول قرمز بهطور موقت متوقف شود (در اثر پاروویروس B19).
- بحران مگالوبلاستیک: به علت کمبود فولات در نتیجه اریتروپوئیز مزمن.
یافتههای آزمایشگاهی / آزمایشهای تشخیصی (Laboratory Findings & Diagnostics)
1. CBC و پارامترهای هماتولوژیک
– Hb و Hct: کاهش متغیر از خفیف تا شدید.
– MCV: طبیعی یا کمی کاهش یافته.
– MCHC: افزایشیافته (اغلب بالای 35 g/dL)؛ یکی از شاخصهای مهم.
– Reticulocyte count: بالا بهعنوان نشانه پاسخ جبرانی مغز استخوان.
2. گسترش خون محیطی (Peripheral Smear)
حضور اسفروسیتها (سلولهای گرد، کوچک و بدون ناحیه روشن مرکزی). پلیکرومازی و آنیزوسیتوز خفیف. در بحران آپلاستیک ممکن است رتیکولوسیتها کاهش یابند.
لام خون محیطی اسفروسیتوز ارثی
3. آزمایشهای بیوشیمیایی مرتبط با همولیز
– بیلیروبین غیرمستقیم: بالا.
– LDH: بالا.
– Haptoglobin: پایین یا صفر (بهعلت مصرف در همولیز).
4. تست شکنندگی اسمزی (Osmotic Fragility Test)
سلولهای کروی نسبت به محلولهای هیپوتون حساستر هستند و زودتر دچار لیز میشوند. اگرچه تست کلاسیک و تاریخی است، ولی امروزه برای تشخیص قطعی به تنهایی کافی نیست.
5. تست EMA Binding (Eosin-5′-maleimide) — روش فلوسایتومتری
روش فلوسایتومتری مبتنی بر اتصال رنگ EMA به پروتئین بند 3 غشای RBC است. در بیماران مبتلا، میزان فلورسانس کاهش مییابد. این روش حساسترین و اختصاصیترین آزمایش برای تشخیص اسفروسیتوز ارثی محسوب میشود.
6. تست کومبس مستقیم (Direct Antiglobulin Test)
همیشه منفی است و همین ویژگی کمک به افتراق از آنمی همولیتیک خودایمنی (AIHA) میکند.
تشخیص افتراقی / Differential Diagnosis
تشخیص اسفروسیتوز باید از سایر شرایطی که با حضور اسفروسیت در خون همراهاند افتراق داده شود:
| بیماری | وجه افتراق |
| آنمی همولیتیک خودایمنی (AIHA) | تست کومبس مستقیم مثبت |
| سوختگیها | سابقه بالینی مشخص |
| سپسیس شدید | یافتههای سیستمیک و کومبس مثبت ممکن است |
بنابراین، تست کومبس مستقیم منفی یکی از معیارهای مهم افتراق اسفروسیتوز ارثی از AIHA است.
درمان / Management (درمان حمایتی و درمان قطعی)
درمان حمایتی (Supportive Care)
– اسید فولیک (1 mg/day): برای حمایت از اریتروپوئیز مزمن.
– هیدراتاسیون کافی: برای پیشگیری از افزایش غلظت بیلیروبین.
– پایش دورهای CBC و بیلیروبین: جهت ارزیابی روند همولیز.
درمان قطعی — اسپلنکتومی (Splenectomy)
اسپلنکتومی باعث توقف یا کاهش چشمگیر همولیز میشود و معمولاً در بیماران با آنمی متوسط تا شدید و علائم واضح انجام میشود. بهترین زمان انجام پس از ۶ سالگی است (برای کاهش خطر عفونتهای پس از جراحی).
احتیاطات پس از اسپلنکتومی
– واکسیناسیون کامل علیه Streptococcus pneumoniae، Neisseria meningitidis، Haemophilus influenzae type b قبل از عمل.
– تجویز آنتیبیوتیک پیشگیرانه (بهویژه در کودکان تا چند سال پس از عمل).
– آموزش بیمار برای مراجعه سریع در صورت تب یا علائم عفونت.
عوارض احتمالی و پیشآگهی / Complications & Prognosis
– سنگ صفراوی پیگمانته: شایعترین عارضه مزمن.
– زردی مزمن: ناشی از بیلیروبین بالا.
– عفونتهای پس از اسپلنکتومی: بهویژه با ارگانیسمهای کپسولدار.
– بحرانهای همولیتیک یا آپلاستیک: معمولاً پس از عفونتها.
با تشخیص بهموقع و درمان صحیح، بیماران اغلب عمر طبیعی دارند. پس از اسپلنکتومی، هموگلوبین معمولاً به سطح طبیعی بازمیگردد و زردی برطرف میشود. در فرمهای خفیف، بدون نیاز به جراحی، فقط پیگیری کافی است. در کودکان کوچک، تأخیر در تشخیص ممکن است باعث تأخیر رشد یا سنگ صفراوی زودرس شود.
نکات تخصصی برای آزمایشگاهها / Laboratory Practical Tips
1. شمارش دقیق رتیکولوسیتها در کنار بررسی اسمیر خون محیطی، در تعیین شدت همولیز اهمیت دارد.
2. مشاهده همزمان MCHC بالا و RDW افزایشیافته به نفع HS است.
3. تست EMA Binding را میتوان برای تشخیص قطعی، بهویژه در موارد خفیف یا بدون علائم خانوادگی استفاده کرد.
4. بررسی خانوادگی (Family screening) توصیه میشود، زیرا فرمهای خفیف در والدین ممکن است تشخیص داده نشده باشند.
5. آمادهسازی نمونه برای تست شکنندگی اسمزی: باید از خون تازه استفاده شود، زیرا تأخیر باعث نتایج منفی کاذب میگردد.
جمعبندی / Conclusion
اسفروسیتوز ارثی نوعی آنمی همولیتیک مادرزادی است که در اثر نقص در پروتئینهای غشای RBC ایجاد میشود. ویژگی بارز آن وجود اسفروسیتها در خون محیطی، افزایش MCHC و تست کومبس منفی است. تشخیص قطعی با تست EMA binding و بررسی ژنتیکی ممکن است. درمان اصلی، اسپلنکتومی در موارد متوسط تا شدید است که با مراقبت مناسب، بیماران میتوانند زندگی طبیعی و طول عمر طبیعی داشته باشند.
❓ سوالات رایج درباره اسفروسیتوز ارثی
1. اسفروسیتوز ارثی چیست؟
اسفروسیتوز ارثی نوعی آنمی همولیتیک مادرزادی است که در اثر نقص در پروتئینهای غشای گلبول قرمز ایجاد میشود. این نقص باعث میشود سلولها به شکل کروی درآیند و در طحال زودتر تخریب شوند.
2. آیا اسفروسیتوز ارثی قابل درمان است؟
درمان قطعی آن با جراحی برداشتن طحال (اسپلنکتومی) امکانپذیر است. در موارد خفیف، درمان حمایتی با اسید فولیک و پیگیری منظم کافی است.
3. اسفروسیتوز ارثی چگونه به ارث میرسد؟
این بیماری معمولاً با الگوی اتوزومال غالب منتقل میشود؛ یعنی وجود ژن معیوب در یکی از والدین برای بروز بیماری کافی است. در موارد نادر، الگوی مغلوب نیز مشاهده میشود.
4. علائم اولیه اسفروسیتوز ارثی چیست؟
زردی پوست و چشم، رنگپریدگی، خستگی، بزرگی طحال و گاهی سنگ صفرا از علائم شایع هستند. در کودکان، زردی مزمن میتواند اولین نشانه بیماری باشد.
5. آیا اسفروسیتوز ارثی خطرناک است؟
در بیشتر موارد بیماری خفیف تا متوسط است، ولی در بحرانهای آپلاستیک یا همولیتیک میتواند خطرناک شود. درمان بهموقع و پیگیری منظم باعث پیشآگهی بسیار خوب میشود.
6. چه آزمایشهایی برای تشخیص اسفروسیتوز ارثی انجام میشود؟
CBC، مشاهده اسفروسیت در اسمیر خون محیطی، تست شکنندگی اسمزی، تست EMA Binding و تست کومبس مستقیم (برای افتراق با AIHA) از مهمترین آزمایشها هستند.
7. آیا کودکان مبتلا به اسفروسیتوز ارثی باید واکسینه شوند؟
بله، پیش از اسپلنکتومی باید واکسیناسیون علیه پنوموکوک، مننگوکوک و هموفیلوس آنفلوآنزا نوع b انجام شود تا خطر عفونتهای شدید پس از عمل کاهش یابد.
8. آیا رژیم غذایی خاصی برای بیماران توصیه میشود؟
رژیم خاصی نیاز نیست اما مصرف اسید فولیک، مایعات کافی و پرهیز از کمخونیهای تغذیهای توصیه میشود. در صورت بروز سنگ صفرا، باید از مصرف چربیهای سنگین پرهیز شود.
9. تفاوت اسفروسیتوز ارثی با آنمی همولیتیک خودایمنی چیست؟
در اسفروسیتوز ارثی تست کومبس مستقیم منفی است و علت آن نقص ژنتیکی غشای RBC است، در حالی که در AIHA، تخریب RBCها توسط آنتیبادیها و با تست کومبس مثبت همراه است.
10. پیشآگهی بیماران مبتلا به اسفروسیتوز ارثی چگونه است؟
در صورت درمان مناسب و مراقبت پس از اسپلنکتومی، بیماران معمولاً زندگی کاملاً طبیعی خواهند داشت. تنها نیاز به پیگیری منظم و واکسیناسیون دارند.
📚 منابع معتبر برای مطالعه بیشتر
© تمامی حقوق این مقاله متعلق به وبسایت Heamostica.com است.
انتشار مطلب با ذکر منبع بلامانع است.